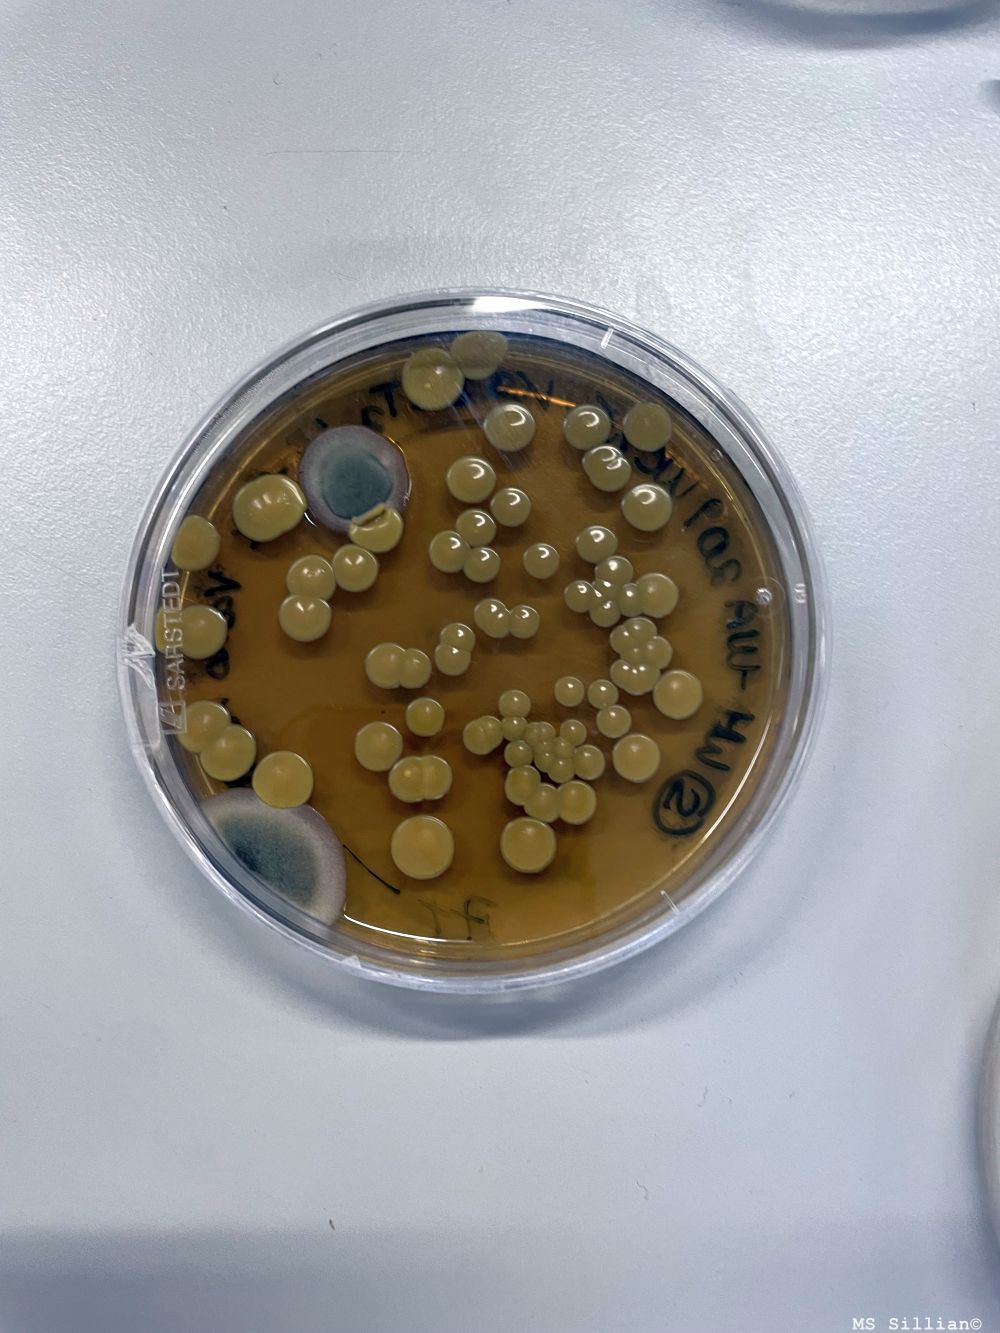

Neuester Bericht ganz unten!
____________________________________________________________________________________________
MINT-Gruppe besucht Workshop „Überall Plastik“
Die MINT-Gruppe unserer Schule nahm kürzlich an einem Workshop zum Thema „Überall Plastik“ teil. Dabei drehte sich alles um Mikroplastik – winzige Kunststoffteilchen, die durch alltägliche Vorgänge wie Autofahren (Abrieb von Reifen) oder Wäschewaschen (Polyesterstoffe) entstehen und in die Umwelt gelangen.
Im praktischen Teil konnten die Schüler*innen beobachten, wie beim Waschen von Polyesterkleidung Mikroplastikfasern ins Abwasser gelangen. Diese wurden gefiltert und mit einer UV-Lampe sichtbar gemacht – ein eindrucksvoller Beweis für die unsichtbare Verschmutzung durch Mikroplastik.
Außerdem führten die Schüler*innen ein biologisches Experiment durch: Sie mischten Hefe mit Nährmedium, verteilten es auf Nährböden und beobachteten, wie sich Bakterien und Pilze auf den Oberflächen ansiedelten.
Der Workshop war ein spannender Einblick in ein aktuelles Umweltproblem und zeigte, wie wichtig bewusster Umgang mit Kunststoffen ist.

____________________________________________________________________________________________
MINT-Gruppe besucht die HTL
Unsere MINT-Gruppe durfte einen spannenden Einblick in die Welt der Technik an der HTL gewinnen. Gemeinsam mit den Schüler:innen der Schule fertigten die Schülerinnen und Schüler einen Kreisel mit LED-Beleuchtung an.
Dabei lernten sie, wie man eine Platine lötet und elektronische Bauteile wie Widerstände richtig einsetzt. Außerdem bekamen die Schüler:innen einen Einblick in die CAD-Software und die CNC-Maschine.
Zum Abschluss des Projekts traten die Kreisel in einem Wettbewerb gegeneinander an – es war spannend zu beobachten, welcher Kreisel sich am längsten drehte. Zwischendurch stärkten sich alle bei einer gemeinsamen Jause und hatten Gelegenheit, ihre Erfahrungen auszutauschen.
Der Besuch an der HTL bot der MINT-Gruppe einen praxisnahen Einblick in Technik, Elektronik und Teamarbeit und machte den Tag zu einem besonderen Erlebnis.





____________________________________________________________________________________________
Von der Erde auf den Teller und in das Labor – unser Kartoffelprojekt in der MINT-Gruppe
Am Ende des letzten Schuljahres haben wir in der MINT-Gruppe Kartoffeln auf einem Acker unseres Lehrers Herr Moser gesetzt. Es war spannend zu sehen, wie aus den kleinen Knollen
im Laufe der Zeit richtige Pflanzen wurden. Nach den Sommerferien konnten wir dann endlich ernten – und das war gar nicht so einfach! Mit Schaufeln und viel Eifer haben wir die Kartoffeln aus der Erde geholt und stolz unsere Ernte bestaunt.
Natürlich wollten wir die Kartoffeln nicht nur anschauen, sondern auch probieren. In der Schulküche haben wir daraus eine leckere Kartoffelsuppe und ein herzhaftes Geröstl gekocht. Außerdem haben wir aus unseren violetten Kartoffeln im Airfryer knusprige Chips gemacht – die sahen nicht nur cool aus, sondern schmeckten auch richtig gut!
Durch das Projekt haben wir nicht nur etwas über Pflanzen und Ernährung gelernt, sondern auch erlebt, wie viel Arbeit und Freude in so einem kleinen Stück Natur steckt.
Doch unser Kartoffelabenteuer ist noch nicht vorbei: Als Nächstes wollen wir mit den Knollen sogar Strom erzeugen! Wir sind schon sehr gespannt, wie das funktioniert – und ob unsere Kartoffeln auch als Energiequelle taugen.






____________________________________________________________________________________________
Wasserforscher an der Drau – Die Wasserschule zu Besuch bei MINT
Die Wasserschule war im Rahmen des MINT-Unterrichts bei uns zu Gast. Gemeinsam mit den Schüler:innen ging es an die Drau, wo sie als junge Wasserforscherinnen und -forscher aktiv wurden.
Mit Pinseln und Bechern ausgestattet, wurden unter Steinen im Flussbett spannende Kleinstlebewesen entdeckt – darunter Eintagsfliegen, Köcherfliegenlarven, Steinfliegenlarven, Strudelwürmer und sogar Larven der Kriebelmücke. Diese sogenannten Zeigerorganismen lassen Rückschlüsse auf die Wasserqualität zu – und die war ausgezeichnet!
Besonders spannend war es, die Tierchen anschließend mit einem Smartscope ganz genau zu betrachten und zu untersuchen. Dabei konnten selbst kleinste Details sichtbar gemacht werden – ein echtes Mikroskopie-Erlebnis!
Abschließend wurde das Wasser der Drau noch auf pH-Wert und Wasserhärte untersucht. Auch hier bestätigten die Messergebnisse: Die Wasserqualität ist hervorragend – fast Trinkwasserqualität!
Ein spannender und lehrreicher Tag, der Naturerlebnis und Wissenschaft ideal miteinander verbunden hat!









____________________________________________________________________________________________
Die Wasserschule zu Besuch – Lehrausgang in den Wald
Im Rahmen des Projekts Wasserschule unternahmen unsere Schülerinnen und Schüler einen spannenden Lehrausgang in den Wald. Dort erfuhren sie viel über die wichtigen Funktionen des Waldes – als Schutzwald, Erholungsraum und Lebensraum für zahlreiche Tiere und Pflanzen. Anhand der Stockwerke des Waldes wurden typische Bewohner vorgestellt, und auch die Bedeutung des Generationenwaldes wurde erklärt: Nur wenn alte, junge und ganz neue Bäume nebeneinander wachsen, kann der Wald langfristig bestehen.
Ein besonderes Erlebnis war das „Baumtelefon“, bei dem die Kinder die Schallleitung durch die Kapillaren eines Baumes ausprobieren konnten. Außerdem erfuhren sie, warum Bäume Harz abgeben und wie Ameisen Harzkugeln als natürlichen „Seuchenteppich“ nutzen, um Pilzsporen von ihrem Haufen fernzuhalten. Auch ein Alltagsbezug wurde hergestellt: Harz ist ein Bestandteil der Zugsalbe.
Im Anschluss wurde der Bärlapp genauer untersucht. In der Klasse führten die Kinder spannende Experimente mit Bärlappsporenpulver durch:
- Das Pulver schwimmt auf Wasser, und wer den Finger eintaucht, bleibt trocken – wegen der wasserabweisenden Oberfläche. Diese Eigenschaft wird auch in der Textiltechnologie genutzt.
- In einem weiteren Versuch wurde gezeigt, wie sich Wassertropfen im Pulver einhüllen und zu kleinen Kugeln rollen lassen.
- Schließlich demonstrierte ein Versuch die hohe Entzündlichkeit des Pulvers.
Abschließend wurde auch die aktuelle Situation des Waldes in Osttirol thematisiert. Als Ursachen für die massiven Waldschäden gelten die Sturmtiefs und nassen Schneefälle der Jahre 2018, 2019 und 2020, die vielerorts große Zerstörungen hinterließen.
Ein lehrreicher Tag, der eindrucksvoll zeigte, wie vielfältig und schützenswert unser Wald ist!















